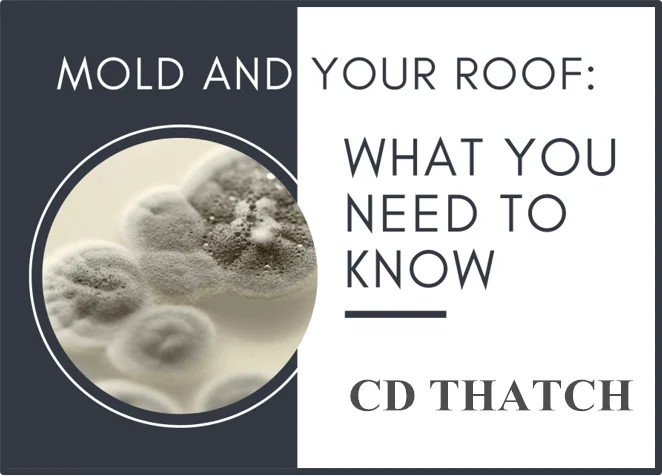
PictureA.png

Artificial Bend Reed Thatch Roof Tiles
- Category: >>>
- Supplier: Xiamen Chuangdun Technology Co. Ltd.
Share on (1600401422525):
Product Overview
Description


| 50x55cm / 100x55cm | |














Xiamen Chuangdun Technology Co Ltd
CD THATCH is professional and original maker of synthetic thatch roof.CD can make synthetic thatch roof, synthetic bamboo pole, fencing & mat etc.
Synthetic thatch panels are a popular alternative to natural thatch.The advantage of CD synthetic thatch panels is that they will last for many years, are fire retardant,
weather resistant and are light enough to handle effectively.Synthetic thatch panels are more expensive than natural thatch panels,
but in the long term are more economical because they don't require maintenance or replacement for many years,
whereas the natural thatch panels will have to be replaced 2-3 times during that time.Synthetic thatch panels are the ideal product for long term thatching needs.
You choose, you enjoy.

We Recommend
New Arrivals
New products from manufacturers at wholesale prices






















